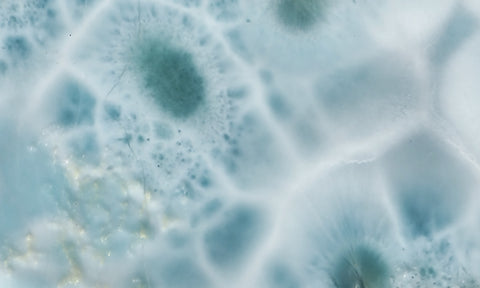

Curiosity Shop Rock Slab 477
The curiosity shop features unique or hard to find items, many of which come from a collector/geologist who was actively trying to amass a comprehensive collection more than twenty years ago. Included are old stock rocks, collector’s pieces, one-offs, rocks from currently depleted mines, or unusual items that do not fit the categories within the store.
LARIMAR
Origin: Dominican Republic
Dimensions: 2" x 2.25" and is approximately 8.6 mm thick. Weight = 59 grams.
Not polished. Shown wet. Known flaws are shown as white lines in the final picture frame.
We Also Recommend